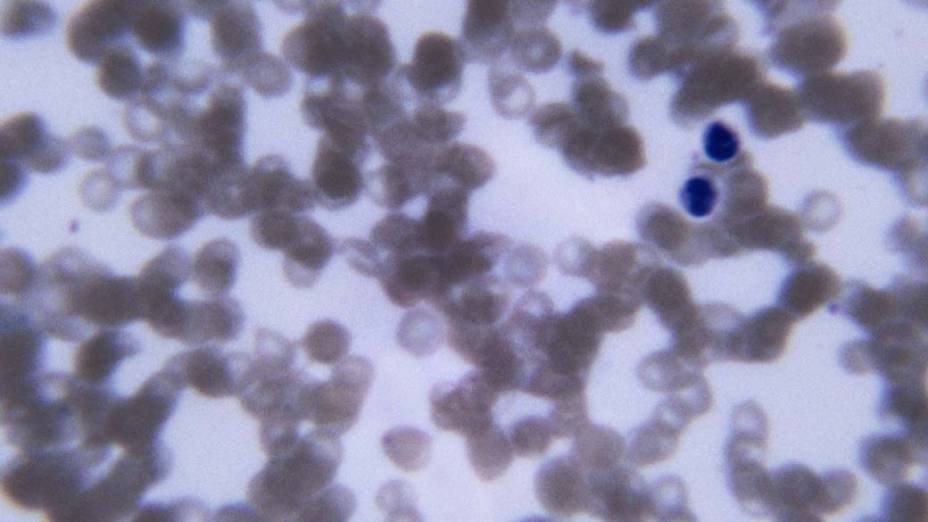
<p></p> <p></p>

Remédio para artrite faz crescer cabelo – e muito – em homem careca
Em estudo nos Estados Unidos, tratamento reverteu calvície em paciente com alopecia universal

Pesquisadores da Universidade Yale, nos Estados Unidos, podem ter descoberto um uso off label (isto é, fora da indicação original da bula) para um remédio indicado para artrite reumatoide: um tratamento contra a calvície. Em um estudo publicado online nesta quinta-feira no periódico Journal of Investigative Dermatology, os cientistas mostraram que a droga citrato de tofacitinibe fez crescer fios – e muitos – em um paciente de 25 anos completamente careca.
Trata-se do primeiro caso de tratamento bem sucedido relatado na medicina para alopecia universal, forma extrema da alopecia areata, distúrbio autoimune que promove queda de cabelo. O remédio fez crescer fios não apenas na cabeça do paciente, mas em regiões como sobrancelha, cílio e axila.
“O resultado é exatamente o que a gente esperava”, afirma Brett A. King, professor assistente de dermatologia da Escola de Medicina da Universidade Yale e autor da pesquisa. “Trata-se de um grande passo no tratamento de pessoas com essa doença (alopecia universal). Embora seja apenas um caso, nós prevíamos o sucesso do tratamento com base no que sabíamos sobre a doença e o remédio. Acreditamos que os mesmos resultados se repetirão em outros pacientes, e pretendemos tentar.”
Além de alopecia universal, o paciente tinha psoríase, uma condição autoimune que causa placas avermelhadas na pele. King decidiu tratar as duas enfermidades com citrato de tofacitinibe, um remédio para artrite reumatoide aprovado em 2012 pela Food and Drug Administration (FDA), agência que regula medicamentos nos Estados Unidos – no Brasil, o medicamento aguarda análise na fila de espera da Anvisa.
Leia também:
“Preferia ter ficado careca”, diz ex-paciente que usava finasterida
Por que ainda existe gente careca?
Em oito meses de tratamento, o cabelo do paciente cresceu totalmente, e não houve relatos de efeitos colaterais. Segundo King, a droga parece impedir o sistema imunológico de atacar os folículos capilares, consequentemente estimulando o crescimento dos fios.